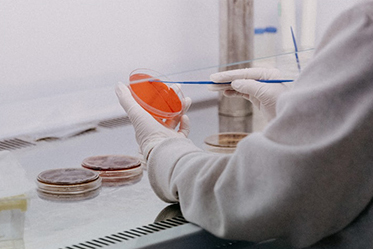

WHAT IS CHELATED?
![]() |
![]() |
![]() |
Chelation is a type of bonding of ions and molecules to metal ions. it involves the formation or presence of two or moreseparate coordinate bonds between a polydentate (multiple bonded) ligand and a single central atom. These ligands areusually organic compounds called chelants, chelators, chelating agents, or sequestering agents.
WHY CHELATED?
Chelation is quite usefu in applications such as providing nutritional supplements.
removing toxic metals from the body with chelation therapy.
◆ Extremely low of heavy metal impurities
◆ Increased bioavailability
◆ lmproved absorption, for example, calcium citrate is widely believed to be more readily absorbed than inorganic calcium salt
◆ Mask metal ion taste
◆ Shield from the effects of other dietary elements
Chelaies are organic molecules that nomaly consist of2 organic pants witn an essenial trace mineral occupying a central posion and held in place by covalent bonding. Sucas Calcium Citrate Calcium Lactate Zinc Gluconate lron sodium EDTA and so on.Amino acid complexes, such as gicinates and methionates, are types of chelates in which the mineralis chelated with an amino acid.Such as ferrous bis-alvcinate. zinemethionine and so on.
|
Full Chelate |
Buffered |
|
Molybdenum Citrate Chelate:0.2%Mo/2%Mo |
Molybdenum Glycinate Chelate:0.2%Mo/2.5%MО |
|
Chromium Nicotinate Glycinate Chelate:2%C |
Selenium Glycinate Complex: 0.2%Se |
|
Zinc Bis-glycinate Chelate:10%Zn |
Boron Glycinate Complex:5%B |
|
Zinc Methionine Chelate:20%Zn |
Magnesium Glycinate:18%Mg Buffered |
|
Zinc Bis-glycinate Chelate: 20%Zn Full Chelat |
|
|
Magnesium Bis-glycinate:11%Mg Full Chelate |
|
|
Manganese Bis-glycinate: 16%Mn Full Chelate |
|
|
Copper Bis-glycinate: 18%Cu Full Chelate |
|
|
Ferrous Bis-glycinate Chelate: 20%Fe Full Chelate |
|
|
Calcium Lactate Gluconate(CLG)(12%Ca) |
|